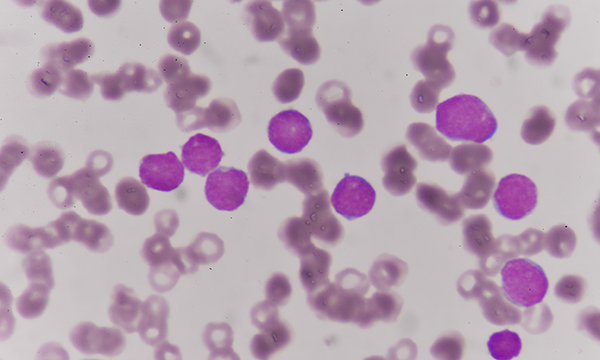
Myelodysplastic syndromes

Myelodysplastic syndromes: update and nursing considerations
This article provides nurses with an update on diagnosis, management and care of patients with myelodysplastic syndromes (MDS), a complex group of disorders of the bone marrow. MDS has wide-ranging effects on patients’ lives. Understanding the effect of a diagnosis of MDS on patients’ quality of life is an important part of the nursing role and includes consideration of physical, mental, emotional and social wellbeing. Many treatment options are available and nurses can educate patients on recognising and managing side effects. While there have been promising developments in management, nurses should ensure that patients and their families have a realistic understanding of MDS and ensure that they are aware that treatments other than haematopoietic stem cell transplantation are non-curative.